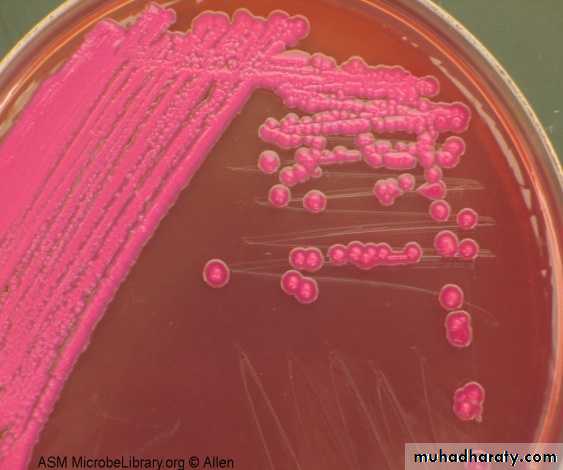
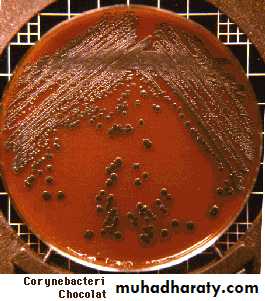
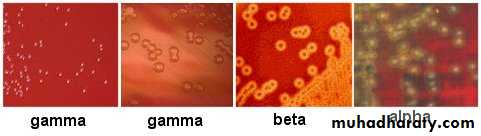
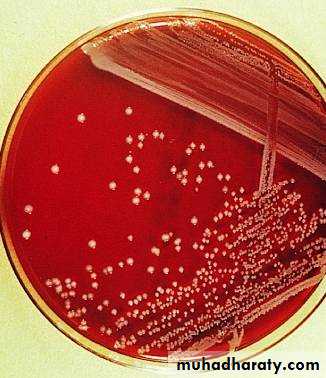
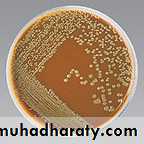

Lab:5
Microbial growth in the laboratoryCulture media
Media: which is used for cultivation of bacteria in order to diagnose the bacteria by the culture characteristics.
The basic requirement of culture media are:-
Energy source (carbon source).
Nitrogen source .
Salts .
Minerals.
Water.
Adjust PH (7.2 to 7.6) .
Adequate oxidation – reduction potential .
In general we can say that culture media are for:
Isolated of pure culture .
Collection of sample .
Growth of microorganism .
Media are solidified by the addition of solidifying agents such as agar. Agar – agar : A complex carbohydrate obtain from Alage used as solidification agent for media. Agar dissolved in aqueous solution, melts at 100 °C, solidifies at 42°C but will remain liquid at 60 °C . agar has no source of nutrients to the bacteria .
Table : Differentiation between agar and Gelatin .
Agar
Gelatin
Agar found in 1.5% in the medium so it is cheap
1. Gelatin found in 15% in the medium so it is expensive
Agar remain unmelted at all incubation tempreture
2. gelatin melt at 25°C
Agar not decomposes by bacteria
3. gelatin decomposes by bacteria
Preparation of culture media:
Dissolving powder media in distilled water and mixing of heater to boiling.
Sterilization of media in auto clave at 121°C and pressure 15 pound for 15-20 min.
Cooling the media and adding the media to petridishes or vials ,wait until solidify, plates are kept inverted
The culture media divided according to physical state to:-
Broth media : used as transport media and for cultivation of bacteria. Contain zero% of agar. Organisms grown in broth cultures are apparent through the turbidity that the large numbers of cells produce in the broth.Semi solid media : used for study the motility of bacteria. Contain 0.2 – 0.5 % agar. On agar, a solid medium, the bacterial cells form masses called colonies after about 18 – 24 hours of growth
Solid media : used to study the all culture characteristics of colony and contain 1-2% agar to solidify the media.
Classification media according to the composition :
Complex media : which is the exact chemical composition is unknown example : plant, animal tissue, egg.Synthetic media : which is the exact chemical composition of medium is known : example: MacCo key agar, Nutrient agar.
Semi synthetic media : in these media the basic media (synthetic media) added a complex substance example : blood, serum, peptone.
Main Types of Media
1-basic media : examples nutrient agar nutrient broth They are usually used for preparation of enriched media To sub-culture pathogens from differential or selective media To do susceptibility testing which used for all groups of bacteria
Nutrient broth (Beef extract, peptone, D.W)
N. agar (N.broth + agar 1-2%)
Semi solid (N.broth + agar 0.2-0.5%
2-Differential media : The addation of certain reagent or chemical to the media may help in differentiating of certain types of bacteria from others.
Ex: MacConkey agar : To differentiate between lactose fermentation and Non lactose fermentation bacteria.
Fermentation of bacteria will below the PH of media by producing acids, the PH indicator Neutral red will recognize the colony to :
Lactose fermentation colony pink color
Ex: E.coli , klebisella spp.
Non lactose fermentation colony pale or colorless
Ex: Salmonella spp. Proteus spp.
3-Selective media : in this media allow the isolation of specific group of bacteria and contain chemical substances that inhibit the growth of one type of bacteria.
For example : crystal violet or bile salt will prevent growth of gram positive bacteria without affecting the growth of gram negative bacteria.
Example of selective media are :-
MacConkey agar : selective media because contain bile salt which inhibit G+ and allow the growth of G- bacteria .
B- Salmonella – shigella agar ssagar
Selective medium inhibition the growth of all bacteria and allow to growth of salmonella and shigellaSelective : high bile salt inhibition G+
Sodium citrate G- (coli form)
And we can differentiate between salmonella and shigella on ssagar Neutral red (indicator)
Salmonella brown colony with black center
Shigella pale or colorlessC-Mannitol Salt agar
contains 7.5% Nacl which inhibition the growth of all bacteria except staphylococci Spp and we can differentiate between Staph spp on this media:Staph aureus Yellow color by fermentation of
manitol4-Enrichment media
Which is used for fastidious bacteria and used by adding blood as a rich substance to the nutrient agar
Example:
Blood agar
Prepare by adding 10% of sterile blood to sterile Nutrient agar at 50°C used human blood or sheep blood.
Blood agar Enrichment and differential because it different between B – haemolysis Str. Pyogens
And α – haemolysis Str. Viridians
Chocolate agar
Prepare by :Adding 10% of sterile blood to the heated Nutrient agar (more than 50°C) and the RbCs will lysis and V and X factors are relased to the media.
By putting the blood agar in oven or in incubator at 55°C or more for 1-2 hours.
5-Special media
Used for one type of bacteriaFor example: Lowenstein – Jensen medium used for the cultivation of Mycobacterium tuberculosis
This contain Malachite green which inhibition all groups of bacteria except Mycobacterium sp. and contain glycerol inhibit M.bovis and allow to growth M. tuberculosis
Classification according to O2 requirements:
Aerobic mediaAll types of media like nutrient agar , N.broth, MacConkey agar, blood agar, chocolate agar ……. Etc)
Which incubate in incubator in aerobic condition
Anaerobic media
These media are used to grow anaerobic organisms.
Ex:, Thioglycolate medium.
: There are special technique for cultivation of anaerobic bacteria:
Candle jar : a burning candle should use up all the O2 before it gets extinguished and provides concentration of carbon dioxide.Macintosh and field jar : inoculated culture plates are placed inside jar and using Gas pak by adding 10ml of water
2H2O + 2NaHCo3 2H2Co3 + 2NaOH
unstable